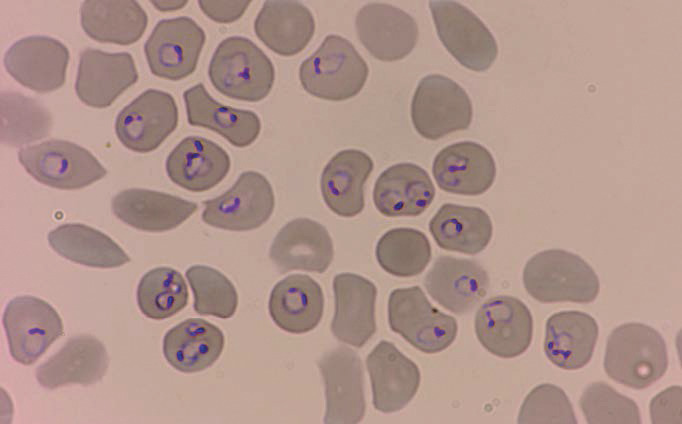

Connaître les circonstances imposant la recherche d’un paludisme et les examens complémentaires permettant de confirmer le diagnostic et d’évaluer le retentissement.
Connaître les critères de gravité, les principes de l’hospitalisation.
Connaître le traitement et les principes de la surveillance d’un accès palustre.
Connaître les principes de la prévention antivectorielle et de la protection médicamenteuse.
Accéder aux sources d’information permettant la mise en œuvre des mesures de prophylaxie adaptées.
Identifier les situations d’urgence et planifier leur prise en charge.
Bien que cette mortalité ait diminué de 30 % entre 2000 et 2020, le nombre de décès dus au paludisme s’élevait encore à environ 629 000 en 2020. La mortalité a été affectée par la crise du Covid-19, avec une augmentation des décès en 2020 de 12 % par rapport à 2019 (558 000).
En France métropolitaine, le nombre de cas de paludisme d’importation déclarés au Centre national de référence (CNR) était de 2 318 en 2021 (avec un nombre total estimé à 4 995 cas), majoritairement à Plasmodium falciparum. Les pays de contamination sont presque exclusivement situés en Afrique subsaharienne. Alors que le nombre de cas déclarés de paludisme d’importation est en constante diminution, le nombre d’accès graves stagne depuis quelques années, et reste élevé à 16,2 % en 2021. Plus de 98 % de ces accès graves sont dus à Plasmodium falciparum et proviennent également quasi exclusivement d’Afrique subsaharienne.
Éléments d’entomologie et de parasitologie
L’anophèle femelle, après avoir été fécondée, pond dans des collections d’eau, et le développement de l’œuf vers un nouvel adulte dure au minimum huit jours. Les anophèles adultes vivent à proximité de la collection d’eau qui leur a donné naissance.
Les femelles, seules potentiellement infectantes, piquent dès la tombée du jour et toute la nuit, et vivent au maximum trente jours.
Il existe cinq espèces plasmodiales : une potentiellement mortelle et la plus largement répandue (P. falciparum) et quatre autres (P. vivax, P. ovale, P. malariae et P. knowlesi).
La vie de Plasmodium peut se diviser en trois cycles, communs aux cinq espèces de Plasmodium (
Cycle sexué, ou étape anophélienne
Cycle asexué hépatique chez l’humain (schizogonie hépatique)
Cycle asexué érythrocytaire chez l’humain (schizogonie érythrocytaire)
Épidémiologie : répartition mondiale du paludisme
P. falciparum est l’espèce plasmodiale la plus répandue dans le monde. Il ne se développe que dans les zones tropicales, en Afrique, en Asie forestière et en Amazonie. P. vivax est le deuxième en fréquence et se répartit entre les latitudes 37° N et 25° S, en Asie, Afrique de l’Est et Amérique centrale et du Sud, tandis que P. ovale est présent principalement en Afrique, surtout dans les zones épargnées par P. vivax, à l’ouest et au centre. Enfin, P. malariae est beaucoup plus rare mais retrouvé sur les trois continents sus-cités, et P. knowlesi est limité aux zones forestières d'Asie du Sud-Est, principalement en Malaisie.
En outre, la climatologie permet de distinguer deux faciès de transmission du paludisme : une zone endémique stable, dans laquelle la transmission se fait toute l’année, en raison d’un climat tropical constant (essentiellement P. falciparum), et une zone d’endémie instable où le paludisme sévit sous forme d’épidémies saisonnières, annuelles ou non, survenant en fonction de la pluviométrie. Ceci concerne les zones tempérées chaudes et surtout P. vivax.
Formes cliniques
Les cinq espèces plasmodiales diffèrent selon des critères parasitologiques (caractéristiques de l’hématie parasitée et du cycle parasitaire) et cliniques (durée d’incubation, complications potentielles, périodicité des accès de reviviscence, délai de survenue des recrudescences tardives). Les différences cliniques sont résumées dans le
Accès de primo-invasion palustre, commun à toutes les formes de Plasmodium
La fièvre est le signe majeur, présent dans 90 % des accès palustres. Elle survient au cours du cycle érythrocytaire, lors de l’hémolyse due à l’éclatement des schizontes dans les hématies, libérant des mérozoïtes dans la circulation. Classiquement, la fièvre est progressivement croissante, peut atteindre plus de 40 °C, et est anarchique (pas de périodicité) car les cycles érythrocytaires sont encore asynchrones. Un tableau pseudogrippal accompagne souvent la fièvre, avec céphalées et signes digestifs (diarrhée, nausées, vomissements…). Chez l’enfant, les signes digestifs peuvent être au premier plan (piège de la gastroentérite fébrile).
Au-delà de ces signes d’appel, l’interrogatoire, étape capitale du diagnostic, doit identifier la durée d’évolution des symptômes et la prise d’antipaludiques, que ce soit en traitement présomptif (risque de frottis et de goutte épaisse « faussement » négatifs) ou en chimioprophylaxie (dont la prise même annoncée comme régulière par le patient ne doit pas faire récuser le diagnostic). En outre, l’examen clinique doit être extrêmement attentif pour détecter précocement des signes de gravité. La fièvre peut être absente lors de l’examen (en dehors du cycle d’hémolyse, en cas de prise d’antipyrétiques ou d’antipaludiques).
En raison de la gravité potentielle d’un accès à P. falciparum méconnu, un principe en médecine des voyages est de considérer que « toute fièvre au retour de zone tropicale est un paludisme jusqu’à preuve du contraire ».
Accès de reviviscence palustre
L’accès comporte trois stades, très stéréotypés : un stade de frissons avec sensation de froid intense et ascension thermique, d’une durée d’une heure ; un stade de chaleur avec un plateau fébrile à 40-41 °C, d’une durée de trois à quatre heures ; un stade de sueurs avec défervescence brutale, d’une durée de deux à quatre heures.
Les accès surviennent par périodes régulières, en fonction de la durée de la schizogonie érythrocytaire (
Accès grave (P. falciparum quasi exclusivement)
Les signes de gravité peuvent être consécutifs à :
- la lyse des hématies dans les capillaires et un phénomène de cyto-adhérence, provoquant une hypoxie des organes concernés : hypoxie cérébrale (troubles de la conscience, convulsions, prostration), atteinte pulmonaire (détresse respiratoire aiguë, œdème pulmonaire lésionnel), atteinte rénale (insuffisance rénale aiguë) ;
- une souffrance viscérale généralisée (hyperlactatémie, acidose, hypoglycémie, collapsus circulatoire) ;
- une hémolyse sévère (anémie sévère, ictère grave).
Autres formes
Diagnostic biologique
Il convient d’associer à un frottis mince :
- une technique sensible en première intention : goutte épaisse, QBC (marquage fluorescent des parasites), ou technique de biologie moléculaire à réponse rapide ;
- un test de diagnostic rapide (TDR) en cas d’indisponibilité des techniques ci-dessus. La sensibilité n'est en revanche pas optimale, et en cas de premier résultat négatif, il est nécessaire de réitérer le test douze à vingt-quatre heures plus tard.
La biologie moléculaire (PCR) est la technique la plus sensible (permet de détecter 0,01 à 1 parasite/µL) et la plus spécifique ; elle représente par conséquent la méthode de référence en cas de difficultés diagnostiques, de suspicion d'infection mixte ou d'infection à P. knowlesi.
Les signes biologiques indirects de paludisme peuvent être d’une grande aide en cas de négativité des tests de détection directs du parasite et de forte présomption clinique. Ils sont consécutifs à l’hémolyse (hyperbilirubinémie libre, lactate déshydrogénase élevée, anémie normocytaire normochrome régénérative), à la séquestration splénique (thrombopénie) et au cycle hépatique (cytolyse). Il n’y a pas d’hyperéosinophilie.
La sérologie n’a pas de place dans l’urgence, mais elle peut être utile pour le diagnostic de certaines formes chroniques.
Un algorithme résume la démarche diagnostique biologique en cas de suspicion de paludisme (
Prise en charge thérapeutique
Ambulatoire ou hospitalisation ?
Prise en charge de l’accès simple à P. falciparum
Un traitement combiné à base de dérivés de l'artémisinine (ACT pour Artemisinin-based Combination Therapy) est recommandé en première intention (arténimol-pipéraquine ou artéméther-luméfantrine).
En cas de contre-indication à ces associations, l’atovaquone-proguanil peut être utilisé en deuxième ligne et la quinine en troisième ligne. La méfloquine n'est plus retenue chez l’adulte en raison de sa mauvaise tolérance clinique, en particulier neuropsychiatrique. Elle reste recommandée en deuxième ligne chez l’enfant.
L’absence de rejet des comprimés, garante de l’efficacité du traitement, est étroitement surveillée. En cas de vomissements, le traitement est basé sur la quinine par voie intraveineuse, avec un relais oral par une ACT (ou atovaquone-proguanil en fonction des éléments cliniques et électrocardiographiques, l’atovaquone-proguanil permettant d'éviter le cumul d’effets indésirables cardiaques) dès l’arrêt des vomissements.
La défervescence thermique, consécutive à la clairance parasitaire, est rapide pour les associations fondées sur les dérivés de l’artémisinine (moins de 48 heures en général). Elle peut être plus prolongée (jusqu’à 72 heures) pour l’association atovaquone-proguanil.
Prise en charge ambulatoire des accès de primo-invasion ou des reviviscences à Plasmodium non falciparum
Un traitement d’éradication par un produit schizonticide hépatique et hypnozoïticide est indiqué dès le premier accès pour P. vivax ou P. ovale afin de limiter le risque de rechute et d’éviter une transmission autochtone dans les zones où des vecteurs potentiels sont présents (par exemple en Corse). Ce traitement repose sur la primaquine (autorisation d'accès compassionnel) à 30 mg/j (ou 0,5 mg/kg/j avec un maximum de 30 mg/j pour les enfants) pendant quatorze jours, après s’être assuré de l’absence de déficit en G6PD, car il existe alors un risque d’anémie hémolytique. Cette complication est recherchée pendant et au décours du traitement, même en l’absence de déficit.
Prise en charge de l’accès palustre avec signes de gravité (P. falciparum ou non)
En cas d’impossibilité de traitement immédiat par artésunate IV, un traitement par quinine IV est entrepris en urgence (dose de charge de 16 mg/kg sur 4 heures, puis, 4 heures plus tard, 8 mg/kg/8 h IV à la seringue électrique), tout en surveillant la glycémie et l’électrocardiogramme. Un traitement symptomatique est associé. Le relais par artésunate IV est entrepris dès que possible, au maximum dans les vingt-quatre heures.
En cas d’accès palustre grave en provenance d’une zone de résistance à l’artésunate (Asie du Sud-Est), le traitement associe l’artésunate à la quinine aux doses habituelles, et dans certains cas à la doxycycline (ou la clindamycine chez la femme enceinte ou l’enfant).
Terrains particuliers
Femmes enceintes
L’artésunate IV peut être utilisé chez la femme enceinte au cours des deuxième et troisième trimestres de grossesse, en raison des bénéfices apportés en matière de morbi-mortalité au cours des accès graves. Au cours du premier trimestre, son utilisation par rapport à celle de la quinine doit être mise en balance à la gravité de l’accès. Les accès simples à P. falciparum comme à P. non falciparum sont traités par quinine orale ou par atovaquone-proguanil en l’absence d’alternative lors du premier trimestre. À partir du deuxième trimestre, l’artéméther-luméfantrine doit être privilégiée. Une surveillance obstétricale est nécessaire dans tous les cas.Enfants
La prise en charge doit systématiquement avoir lieu en milieu hospitalier pour tout type d’accès à P. falciparum, du fait de la fréquence des troubles digestifs et de l’aggravation potentiellement rapide. En cas d’accès grave, la prise en charge est identique à celle de l’adulte (artésunate IV), sans limite inférieure d’âge. En cas d’accès simple, le traitement se fait en première intention par une ACT (artéméther-luméfantrine, arténimol-pipéraquine). L’atovaquone-proguanil et la méfloquine sont des médicaments de deuxième intention (Surveillance de l’efficacité et de la tolérance
Prévention du paludisme
Protection personnelle antivectorielle
Chimioprophylaxie antipaludique
Le détail de la liste des pays (et des zones à risque localement) ainsi que les modalités de prophylaxie recommandées sont mis à jour annuellement par la commission spécialisée maladies infectieuses, maladies émergentes (CSMIME) du Haut Conseil de la santé publique et paraissent chaque année en juin dans le Bulletin épidémiologique hebdomadaire (BEH) publié par Santé publique France.
Les trois options de chimioprophylaxie recommandées (atovaquone-proguanil, doxycycline, méfloquine) sont résumées dans le
En cas de voyages fréquents ou d’expatriations prolongées (plus de 6 mois) avec difficultés d’accès à un diagnostic rapide, la prescription d’un traitement de réserve (traitement présomptif d’urgence) peut être discutée. Il utilise une des associations du
Développement vaccinal
POINTS FORTS À RETENIR
Le paludisme est une maladie parasitaire due à un protozoaire intracellulaire, Plasmodium, transmis par la piqûre d’un moustique infectant, l’anophèle femelle.
Il sévit dans les zones tropicales et subtropicales, majoritairement en Afrique, où il représente la première cause de mortalité des enfants de moins de 5 ans.
Les voyageurs vers les zones endémiques palustres sont également exposés à cette maladie. Il convient donc : – de connaître les moyens de sa prévention, associant une chimioprophylaxie et une protection personnelle antivectorielle ; – d’évoquer systématiquement un paludisme chez un voyageur fébrile au retour de zone d’endémie, ce d’autant que l’accès palustre peut être plus grave chez un individu non immun.
Parmi les cinq espèces de Plasmodium connues à ce jour, une, P. falciparum, est prépondérante et peut s’accompagner de formes graves potentiellement mortelles. Il est donc impératif d’en faire le diagnostic en urgence, en associant un frottis sanguin et une goutte épaisse, un QBC ou une technique de biologie moléculaire rapide, voire éventuellement un test de diagnostic rapide, d’en rechercher les signes de gravité et d’en assurer une prise en charge thérapeutique urgente dans un environnement adapté à la forme clinique observée.
L’évolution des résistances de Plasmodium aux antipaludiques impose une mise à jour régulière des recommandations thérapeutiques : il est donc impératif de bien connaître une source fiable d’information sur ces recommandations, le Bulletin épidémiologique hebdomadaire (BEH).
Paludisme
L’item n° 170 « Paludisme » pourrait faire l’objet d’un dossier clinique entier ou d’une grande partie d’un dossier tant les différents aspects qui le constituent relèvent de la pratique quotidienne en pathologie infectieuse et tropicale, ou du moins doivent relever de « réflexes quasi monosynaptiques », en particulier pour ce qui concerne les modalités de diagnostic au retour de voyage, ou le caractère urgent de la prise en charge, qui sont des messages clés.
Ce dossier entier pourrait en effet aborder de façon successive :
– le volet diagnostique au retour, qui permet en outre d’aborder dans une question inaugurale les éventuels diagnostics différentiels (vus dans l’item « Voyage en pays tropical ») : il est impératif de penser systématiquement au diagnostic de paludisme, en cas de fièvre survenant au cours des trois mois suivant un retour de zone d’endémie, même en cas de chimioprophylaxie bien conduite. Il faut donc en connaître les moyens de diagnostic direct et indirect et surtout le caractère urgent de ce diagnostic ;
– le volet d’évaluation et thérapeutique.Une fois le diagnostic suspecté (puis établi), il faut savoir évaluer la présence ou non de signes de gravité nécessitant un avis réanimatoire au moindre doute (ou une hospitalisation en réanimation) ou, au contraire, la présence de tous les critères de prise en charge ambulatoire. Cette prise en charge relève d’un algorithme très précis, à connaître. Ensuite, il faut connaître les modalités du traitement et de sa surveillance, clinique et biologique. On peut aussi imaginer une question qui porterait sur une rechute à long terme (1 ou 2 ans après l’accès de primo-invasion), faisant diagnostiquer un accès de reviviscence à P. vivax ou P. ovale, et évoquer les modalités du traitement d’éradication par primaquine ;
– le volet préventif pourrait là encore s’inscrire dans le cadre plus général du conseil aux voyageurs, avec les vaccinations et les autres conseils avant un nouveau séjour en zone tropicale (abordé dans l’item « Voyage en pays tropical ») et donner lieu à une ou plusieurs sous-questions.
Il faut connaître les modalités de la prévention, en particulier l’usage de la protection personnelle antivectorielle (qui est aussi utile pour la protection contre d’autres risques vectoriels), en plus de l’éventuelle chimioprophylaxie antipaludique.
À défaut de connaître précisément toutes les zones de résistance aux antipaludiques, il faut absolument connaître (et citer !) les sources d’information fiables qui traitent de cette question.
Enfin, cet item peut permettre de se raccrocher à d’autres modules au travers de la prise en charge de catégories de personnes particulières : les femmes enceintes et les jeunes enfants en particulier, qui relèvent de spécificités de prise en charge à connaître, tant en curatif qu’en prophylactique.
BEH. Recommandations sanitaires aux voyageurs. https://vu.fr/jVwV
Société de médecine des voyages et Société française de parasitologie. Recommandations de bonnes pratiques cliniques (texte court). Protection personnelle antivectorielle. https://vu.fr/agdW
Rapport d'activités CNR paludisme 2021 https://vu.fr/UQCy

 Encadrés
Encadrés